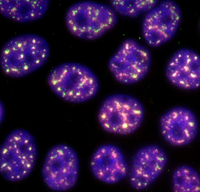

Speakers
-
 9:00 am - 5:00 pm 9/16/2022 - 5/12/2023346 Main University Library, 1408 W. Gregory Dr.
9:00 am - 5:00 pm 9/16/2022 - 5/12/2023346 Main University Library, 1408 W. Gregory Dr.RBML's fall exhibit featuring the University of Illinois Library's extensive Conde de Montemar letters collection, as well as other rare and fascinating books about the 16th-Century Spanish conquest and colonization of Perú.
-
 All Day 12/2/2022 - 2/2/2023
All Day 12/2/2022 - 2/2/2023 -
 12:00 pm 1/30/2023 - 2/3/2023Workshops are offered in-person (Main Library + Grainger Engineering) and online (via Zoom, link included in registration confirmation and reminder emails)
12:00 pm 1/30/2023 - 2/3/2023Workshops are offered in-person (Main Library + Grainger Engineering) and online (via Zoom, link included in registration confirmation and reminder emails) -
 All Day 2/1/2023 - 2/24/2023
All Day 2/1/2023 - 2/24/2023 -
 2:00 - 2:50 pm 2/1/2023UIUC: 190 Engineering Sciences Building | SLAC: 335 McCullough Building
2:00 - 2:50 pm 2/1/2023UIUC: 190 Engineering Sciences Building | SLAC: 335 McCullough Building -
 3:00 - 4:00 pm 2/1/2023114 Transportation Building, 104 S. Mathews Avenue, Urbana, IL
3:00 - 4:00 pm 2/1/2023114 Transportation Building, 104 S. Mathews Avenue, Urbana, ILLectures and discussions on current work in research and development in nuclear engineering and related fields by staff, advanced students, and visiting speakers.
-
 4:00 pm 2/1/2023Loomis Lab 141 and via Zoom
4:00 pm 2/1/2023Loomis Lab 141 and via Zoom -
 12:00 - 1:00 pm 2/2/2023
12:00 - 1:00 pm 2/2/2023Join us online on the first Thursdays of the month from 12pm-1pm as we welcome new faculty, new stories, and new ways of thinking about the art of teaching.
-
 12:00 pm 2/2/2023464 Loomis
12:00 pm 2/2/2023464 Loomis -
 12:00 pm 2/2/2023International & Area Studies Library, Room 309, or on Zoom
12:00 pm 2/2/2023International & Area Studies Library, Room 309, or on Zoom -
 12:00 pm 2/2/2023La Casa Cultural Latina (1203 W Nevada St, Urbana, IL 61801) or on Zoom
12:00 pm 2/2/2023La Casa Cultural Latina (1203 W Nevada St, Urbana, IL 61801) or on ZoomDr. González-Martin (University of Texas at Austin) will talk about an extension of her award-winning book, Quinceañera Style, exploring the tensions and opportunities between celebration and commodification of this important rite of passage. Register for Zoom, or attend in person at La Casa Cultural Latina.
-
 1:00 pm 2/3/2023ESB 190
1:00 pm 2/3/2023ESB 190 -
 1:00 pm 2/3/2023Coble Hall 306
1:00 pm 2/3/2023Coble Hall 306 -
 3:00 pm 2/3/2023Room 242 - School of Information Sciences Building
3:00 pm 2/3/2023Room 242 - School of Information Sciences Building -
 9:00 am - 3:00 pm 2/4/2023
9:00 am - 3:00 pm 2/4/2023Open to faculty and graduate students of any discipline at the University of Illinois Urbana-Champaign. In this workshop you'll unravel the mysteries of your writing barriers, then spend the rest of the day writing and reflecting with other retreaters. And you'll be supported throughout the day by live coaching with InkWell Founder, Michelle Boyd, PhD.
-
 2:00 - 3:30 pm 2/4/2023Urbana Public Library, Sattherhwaite Conference Room
2:00 - 3:30 pm 2/4/2023Urbana Public Library, Sattherhwaite Conference Room -
 4:00 pm 2/4/2023Levis Faculty Center (919 W. Illinois Street), Room 422
4:00 pm 2/4/2023Levis Faculty Center (919 W. Illinois Street), Room 422Courtney Becks, African American and Jewish Studies Librarian, will share a table reading of a work in progress, her play The Socialization of Love.
-
 12:00 pm 2/6/2023190 ESB
12:00 pm 2/6/2023190 ESB -
12:00 - 12:30 pm 2/6/2023Charles G. Miller Auditorium, B102, CLSL
12:00 - 12:30 pm 2/6/2023Charles G. Miller Auditorium, B102, CLSL"The role of nuclear-enriched long non-coding RNA in hypoxia response and cancer progression"
-
 12:30 - 1:00 pm 2/6/2023Charles G. Miller Auditorium, B102, CLSL
12:30 - 1:00 pm 2/6/2023Charles G. Miller Auditorium, B102, CLSL"Role of RNA Helicase MOV10 and its phosphorylation in mRNA regulation."
-
 3:30 pm 2/6/2023Coble Hall, Room 306
3:30 pm 2/6/2023Coble Hall, Room 306 -
 11:00 - 11:50 am 2/7/2023190 Engineering Sciences Building, 1101 W Springfield Ave, Urbana, IL 61801
11:00 - 11:50 am 2/7/2023190 Engineering Sciences Building, 1101 W Springfield Ave, Urbana, IL 61801Speaker: Jong Yeon Lee, University of California Santa Barbara
-
 12:00 - 1:00 pm 2/7/2023
12:00 - 1:00 pm 2/7/2023 -
 12:00 pm 2/7/2023306 Coble Hall
12:00 pm 2/7/2023306 Coble Hall -
 2:00 - 3:00 pm 2/7/20231253 S. Halstead, Chicago, IL 60607
2:00 - 3:00 pm 2/7/20231253 S. Halstead, Chicago, IL 60607 -
 2:00 - 3:00 pm 2/7/2023This is a hybrid event offered on Zoom and at IGPA's Chicago Office at 1253 S. Halstead, Chicago, IL 60607.
2:00 - 3:00 pm 2/7/2023This is a hybrid event offered on Zoom and at IGPA's Chicago Office at 1253 S. Halstead, Chicago, IL 60607.This event is held in partnership with the European Union Center and the Women and Gender in Global Perspectives Program. The discussion will be led by two women who are experts in gender discrimination and are working in high-profile roles on these issues at the United Nations
-
 3:45 pm 2/7/2023Kaler Classroon, Astronomy Building
3:45 pm 2/7/2023Kaler Classroon, Astronomy Building -
 7:30 pm 2/7/2023Levis Faculty Center, Room 300
7:30 pm 2/7/2023Levis Faculty Center, Room 300Futurity, or the intentional imagining and materializing of liberated futures—where freedom from oppression, trauma, violence, and discrimination are realized—inspires this talk. Dr Johnson will discuss their methods for conjuring the world and communities in which we want to live and thrive
-
 4:00 pm 2/8/2023Loomis Lab 141 and via Zoom
4:00 pm 2/8/2023Loomis Lab 141 and via Zoom -
 5:00 pm 2/8/2023422 Levis Faculty Center
5:00 pm 2/8/2023422 Levis Faculty CenterDr. Robert W. Barrett, Jr., University of Illinois, English, "Cherry Trees and More-than-Human Animacies in Zeami's Saigyō-zakura and the N-Town Nativity"
-
 11:00 am 2/9/2023Charles Miller Auditorium, B102, CLSL
11:00 am 2/9/2023Charles Miller Auditorium, B102, CLSLAssistant Professor, Cancer Biology
-
 12:00 - 1:00 pm 2/9/2023Levis Faculty Center, Room 424
12:00 - 1:00 pm 2/9/2023Levis Faculty Center, Room 424This participatory workshop aims to disrupt modes of "doing" scholarly analysis of visual art, performance, film and other cultural productions. Advance registration is required.
-
 12:00 - 1:00 pm 2/9/2023Main Library at 1408 W Gregory Dr. Room 146, Urbana, IL 61801
12:00 - 1:00 pm 2/9/2023Main Library at 1408 W Gregory Dr. Room 146, Urbana, IL 61801 -
 12:00 pm 2/9/2023Main Library, Room 220
12:00 pm 2/9/2023Main Library, Room 220The Storytelling Series seeks to highlight the journeys of our faculty. This session will feature Dr. Christina Bollo, Assistant Professor in the School of Architecture as our storyteller for February. The Storytelling Series will be offered in a hybrid format, both in-person in the Main Library, Room 220 (limited capacity) and via Zoom. Registration required.
-
 1:00 pm 2/9/2023241 Altgeld Hall
1:00 pm 2/9/2023241 Altgeld Hall -
 3:00 - 4:30 pm 2/9/2023School of Information Sciences Building, Room 242
3:00 - 4:30 pm 2/9/2023School of Information Sciences Building, Room 242 -
 4:00 pm 2/9/2023Levis Faculty Center, Room 108
4:00 pm 2/9/2023Levis Faculty Center, Room 108This seminar with curator, writer, and Ethnic Studies scholar Dr. Thea Quiray Tagle will cover different models of working with BIPOC visual artists that challenge the alienating norms behind much art historical scholarship and curatorial practice.
-
 4:00 pm 2/9/2023Coble Hall 306
4:00 pm 2/9/2023Coble Hall 306 -
 5:00 pm 6:00pm 2/9/2023200 S. Wacker Drive, Suite 707, Chicago, IL 60606
5:00 pm 6:00pm 2/9/2023200 S. Wacker Drive, Suite 707, Chicago, IL 60606 -
 6:00 - 8:00 pm 2/9/2023Krannert Art Museum, Main Level, Cafe, 500 E Peabody Dr, Champaign, Illinois 61820
6:00 - 8:00 pm 2/9/2023Krannert Art Museum, Main Level, Cafe, 500 E Peabody Dr, Champaign, Illinois 61820 -
 1:00 - 4:00 pm 2/10/2023i-hotel and Conference Center | Lincoln Room
1:00 - 4:00 pm 2/10/2023i-hotel and Conference Center | Lincoln RoomThis Meet & Greet, open to all Illinois faculty, staff, and students, marks the launch of the Food Security Working Group, a campus-wide initiative to support those interested in getting connected to this work, as well as research resources for those interested in food security.
-
 10:00 - 10:30 am 2/11/2023Champaign Public Library, Nate & Lillie Story Room (200 W. Green St., Champaign, IL 61820)
10:00 - 10:30 am 2/11/2023Champaign Public Library, Nate & Lillie Story Room (200 W. Green St., Champaign, IL 61820) -
 7:30 pm 2/11/2023Recital Hall, Smith Memorial Hall. 1114 W. Nevada St., Urbana
7:30 pm 2/11/2023Recital Hall, Smith Memorial Hall. 1114 W. Nevada St., Urbana -
 12:00 pm 2/13/2023Charles G. Miller Auditorium B102 CLSL
12:00 pm 2/13/2023Charles G. Miller Auditorium B102 CLSL -
 12:00 - 12:50 pm 2/13/2023Main Library 314 and online (via Zoom, links will be sent to registrants one hour before the session)
12:00 - 12:50 pm 2/13/2023Main Library 314 and online (via Zoom, links will be sent to registrants one hour before the session) -
 11:00 am 2/14/2023Altgeld Hall 243
11:00 am 2/14/2023Altgeld Hall 243 -
 11:00 - 11:50 am 2/14/2023190 Engineering Sciences Building, 1101 W Springfield Ave, Urbana, IL 61801
11:00 - 11:50 am 2/14/2023190 Engineering Sciences Building, 1101 W Springfield Ave, Urbana, IL 61801 -
 12:00 - 1:00 pm 2/14/2023
12:00 - 1:00 pm 2/14/2023 -
 12:00 pm 2/14/2023612 IGB Conference Center, 1206 West Gregory Drive, Urbana, IL
12:00 pm 2/14/2023612 IGB Conference Center, 1206 West Gregory Drive, Urbana, IL -
 12:00 pm 2/14/2023Lincoln Hall 1065 (702 S. Wright St., Urbana, IL 61801)
12:00 pm 2/14/2023Lincoln Hall 1065 (702 S. Wright St., Urbana, IL 61801) -
 12:00 pm 2/14/20231065 Lincoln Hall (702 S. Wright St., Urbana, IL 61801)
12:00 pm 2/14/20231065 Lincoln Hall (702 S. Wright St., Urbana, IL 61801) -
 12:00 pm 2/14/2023Coble Hall 306
12:00 pm 2/14/2023Coble Hall 306 -
 12:00 - 12:45 pm 2/14/2023Asian American Cultural Center, 1210 W. Nevada St. Urbana
12:00 - 12:45 pm 2/14/2023Asian American Cultural Center, 1210 W. Nevada St. Urbana -
 3:45 pm 2/14/2023Kaler Classroon, Astronomy Building
3:45 pm 2/14/2023Kaler Classroon, Astronomy Building -
 4:00 pm 2/14/20231005 Forbes Natural History Building, 1816 S Oak Street, Champaign
4:00 pm 2/14/20231005 Forbes Natural History Building, 1816 S Oak Street, Champaign -
 4:00 - 4:50 pm 2/14/20231310 Digital Computer Laboratory, 1304 W. Springfield Avenue, Urbana, IL
4:00 - 4:50 pm 2/14/20231310 Digital Computer Laboratory, 1304 W. Springfield Avenue, Urbana, ILLectures and discussions on current work in research and development in nuclear engineering and related fields by staff, advanced students, and visiting speakers.
-
 5:30 - 7:00 pm 2/14/2023Art & Design room 331
5:30 - 7:00 pm 2/14/2023Art & Design room 331 -
 7:00 - 9:00 pm 2/14/2023Spurlock Museum Knight Auditorium (600 S Gregory St, Urbana, IL 61801)
7:00 - 9:00 pm 2/14/2023Spurlock Museum Knight Auditorium (600 S Gregory St, Urbana, IL 61801) -
 7:00 - 9:00 pm 2/14/2023Spurlock Museum Knight Auditorium (600 S Gregory St, Urbana, IL 61801)
7:00 - 9:00 pm 2/14/2023Spurlock Museum Knight Auditorium (600 S Gregory St, Urbana, IL 61801) -
 7:30 pm 2/14/2023Krannert Center for the Performing Arts
7:30 pm 2/14/2023Krannert Center for the Performing Arts -
 12:00 - 12:30 pm 2/15/2023Charles G. Miller Auditorium, B102 CLSL
12:00 - 12:30 pm 2/15/2023Charles G. Miller Auditorium, B102 CLSL -
 12:30 - 1:00 pm 2/15/2023Charles G. Miller Auditorium, B102 CLSL
12:30 - 1:00 pm 2/15/2023Charles G. Miller Auditorium, B102 CLSL -
 4:00 pm 2/15/2023Loomis Lab 141 and via Zoom
4:00 pm 2/15/2023Loomis Lab 141 and via Zoom -
 7:00 - 8:30 pm 2/15/2023Heritage Hall, I Hotel and Conference Center (1900 1st St., Champaign)
7:00 - 8:30 pm 2/15/2023Heritage Hall, I Hotel and Conference Center (1900 1st St., Champaign)Join us for a campus-community town hall with a panel of experts on political polarization to answer your questions. We will reflect on how we got here and what we can do to move forward.
-
 7:00 - 8:30 pm 2/15/2023Heritage Hall, I Hotel and Conference Center (1900 1st St., Champaign)
7:00 - 8:30 pm 2/15/2023Heritage Hall, I Hotel and Conference Center (1900 1st St., Champaign)Join us for a campus-community town hall with a panel of experts on political polarization to answer your questions. We will reflect on how we got here and what we can do to move forward.
-
 7:00 - 8:30 pm 2/15/2023I Hotel and Conference Center, Heritage Room, 1900 S. 1st Street, Champaign
7:00 - 8:30 pm 2/15/2023I Hotel and Conference Center, Heritage Room, 1900 S. 1st Street, ChampaignConcerned about divisive politics? Join us for a campus-community town hall with a panel of experts on political polarization to answer your questions. We will reflect on how we got here and what we can do to move forward. For more information and to register:go.illinois.edu/BraverAngels. Registration would be appreciated by February 8.
-
 11:00 am 2/16/2023Charles Miller Auditorium, B102, CLSL
11:00 am 2/16/2023Charles Miller Auditorium, B102, CLSLAssociate Professor, Dept. Psychological and Brain Sciences
-
 11:00 am - 12:00 pm 2/16/2023
11:00 am - 12:00 pm 2/16/2023Join us on Zoom as we explore Turkish Coffee, and let's establish a forty-year friendship while having Turkish Coffee together. We'll walk you through this Turkish tradition step by step, and you'll even be able to play Turkish coffee trivia for the chance to win your own Turkish coffee set.
-
 12:00 - 1:00 pm 2/16/2023
12:00 - 1:00 pm 2/16/2023In this inaugural session of the CSBS Social and Behavioral Health Funding Series, Dr. Bill Elwood, NIH Health Scientist Administrator, will discuss an upcoming NIH funding opportunity focused on social relationships and health.








